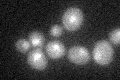
YLR228C
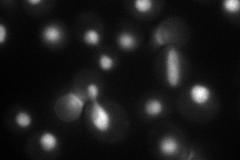
YLR228C
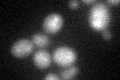
YLR228C

View description
Sterol regulatory element binding protein, regulates transcription of sterol biosynthetic genes; contains Zn[2]-Cys[6] binuclear cluster; homologous to Upc2p; relocates from intracellular membranes to perinuclear foci on sterol depletion
Localization:
Intensity:
Fold change:
Significance:
-
C’ GFP library in SD
nucleus20.11 -
N' NOP1pr-GFP in SD
nucleus66.919 -
N' TEF2pr-mCherry in SD

nucleus88.6229 -
N' NATIVEpr-GFP in SD

nucleus25.9713 -
N' TEF2pr-VC and Cyto-VN in SD

nucleus44.472 -
C’ GFP library in SD+DTT
nucleus20.251No -
C’ GFP library in SD+H2O2

nucleus18.660.92No -
C’ GFP library in Starvation Media

nucleus16.960.84No -
C’ GFP library on the background of Pup2-DaMP

nucleus -
C’ GFP library on the background of CCT mutant

nucleus20.78071.03305No
